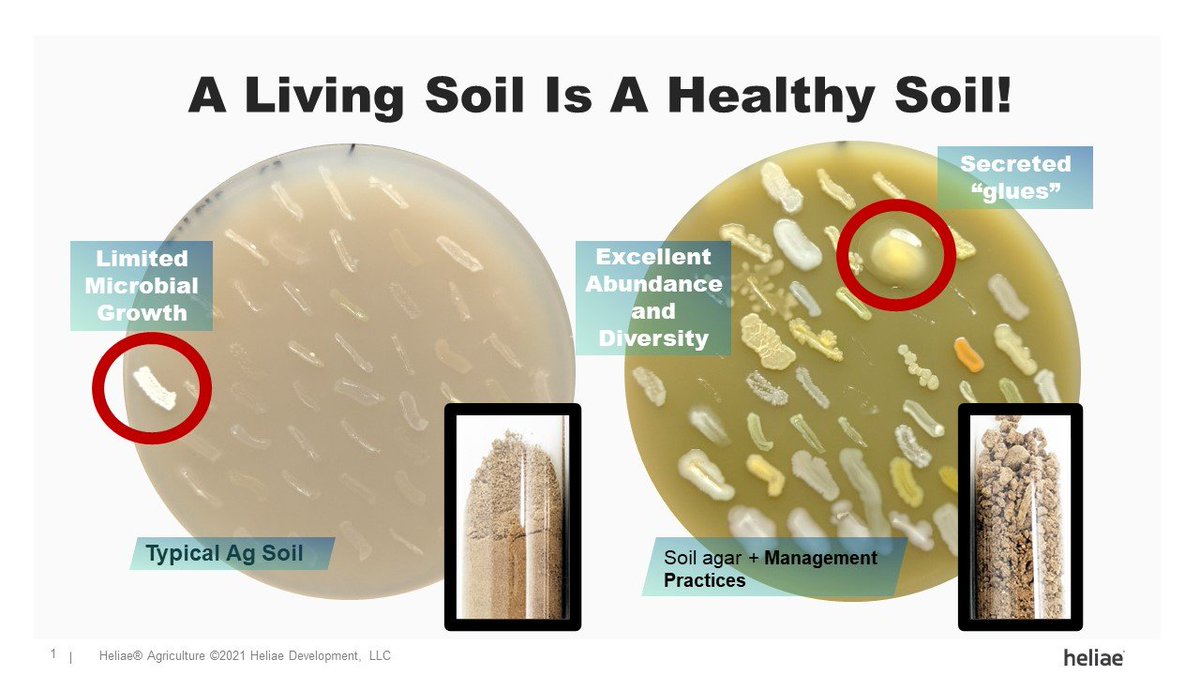

Seguimos con la importancia de los suelos vivos y su capacidad de secuestro de carbono.
Pero, ¿cuál es el mecanismo que permite almacenar el CO2 de la atmósfera en el suelo?
Hoy hablaremos de la Bomba Microbiana de Carbono 🧵
Pero, ¿cuál es el mecanismo que permite almacenar el CO2 de la atmósfera en el suelo?
Hoy hablaremos de la Bomba Microbiana de Carbono 🧵

1⃣ El secuestro de carbono es el proceso de capturar CO2 de la atmósfera y almacenarlo en material vegetal o suelo.Para que pueda darse el secuestro de carbono en el suelo, el balance entre el CO2 absorbido y el emitido, debe de ser positivo 

2⃣ Y para que esto se produzca, es fundamental la existencia en el suelo de microagregados que veíamos en el anterior hilo
https://twitter.com/DavidSustraiak/status/1558886274186051594
3⃣ En estos espacios la materia orgánica se une a los minerales del suelo formando asociaciones organominerales que protegen físicamente las reservas de carbono del suelo 

4⃣ Hasta no hace mucho, se pensaba que este carbono orgánico del suelo estaba formada por unas cadenas largas de compuestos poliméricos, formados a través de la condensación o humificación de materiales recalcitrantes de origen vegetal o animal. A esto le llamamos HUMUS 

5⃣ Actualmente, la utilización de tecnologías de observación directa de alta resolución de los agregados o de los minerales del suelo, ha encontrado que se trata de moléculas o estructuras muy simples y no complejos polímeros lo que forma la materia orgánica estable 

6⃣Estas moléculas simples, provendrían de la necromasa de los microorganismos y pueden permanecer largos períodos en suelo, no tanto por la capacidad recalcitrante del material, sino por su accesibilidad. Es decir, la MOS permanece estable si tiene una protección física adecuada
7⃣Para entender la protección en agregados y almacenamiento a largo plazo, debemos detenernos en los procesos microbiano que lo permiten. Parte de la glucosa producida en la fotosíntesis, es exudada por las raíces, alimentando la microbiota, aumentando las comunidades microbianas 

8⃣ Cuando esas bacterias y especialmente los hongos mueren, sus restos formados principalmente de una forma de carbono denominada quitina, pasan a formar parte de la MOS estable del suelo, estabilizándose en la superficie de los minerales dentro de los agregados 

9⃣Por lo tanto, los microorganismos tienen una doble influencia. Por un lado, contribuyen a la mineralización de reservas de carbono para obtener energía, pero por otro, contribuyen a su aumento a través de la biomasa microbiana durante los procesos de anabolismo
🔟y la estabilización de sus residuos dentro de las estructuras del suelo. Así, el carbono orgánico más persistente podría no estar compuesto de desechos de plantas, sino estar formado por carbono que ha pasado primero por la biomasa microbiana 

1⃣1⃣En el proceso de bomba de carbono microbiana, la necromasa microbiana puede asociarse con los minerales del suelo formando compuestos organominerales que permiten la protección física y, por tanto, la estabilidad de la MOS. 

1⃣2⃣La comprensión del ciclo del carbono de los microorganismos del suelo, es de gran relevancia para conocer la persistencia largo plazo de su necromasa y su relación con el CO2 atmosférico y cómo gestionar la productividad agrícola 

1⃣3⃣De ello se deriva que si queremos secuestrar una mayor cantidad de carbono en el suelo, tendremos que promover el crecimiento microbiano, más producción de biomasa microbiana y más necromasa que forme asociaciones con los minerales que estabilicen el carbono orgánico.
1⃣4⃣Cuando se hace una fertilización sintética, se utiliza para alimentar directamente a la planta (las raíces) con nutrientes solubles y por ello, las raíces son muy poco profundas. No necesitan bajar mucho para conseguir los nutrientes protegidos en la materia orgánica. 

1⃣5⃣En fertilización orgánica utilizamos cultivos de cobertura que reponen la materia orgánica del suelo o estiércol o compost. Estas formas de nitrógeno o carbono orgánico, son las que necesitan los microorganismos para crecer y aumentar su biomasa y construir más reservas de C 

Si te interesan todos estos temas, te invito a seguir mi blog: Agricultura de Carbono
agriculturadecarbono.wordpress.com
agriculturadecarbono.wordpress.com
• • •
Missing some Tweet in this thread? You can try to
force a refresh
















